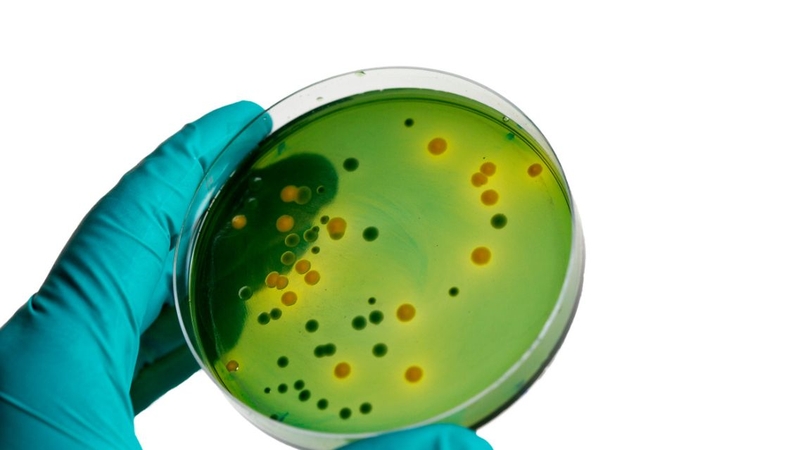
Bác sĩ chỉ định thực hiện xét nghiệm cấy mủ khi tổn thương có mủ kéo dài
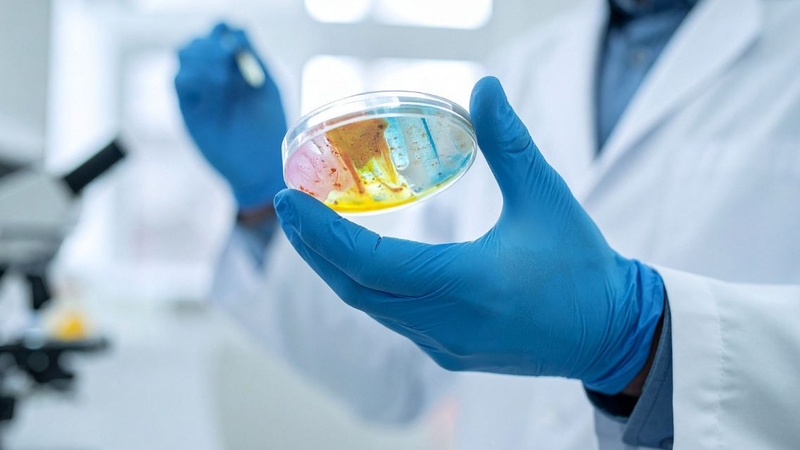
Phòng xét nghiệm đạt tiêu chuẩn giúp đảm bảo quy trình cấy mủ chính xác

Tốt nghiệp Đại học Y Dược TP. Hồ Chí Minh. Có nhiều năm trong lĩnh vực dược phẩm. Hiện đang là giảng viên cho Dược sĩ tại Nhà thuốc Long Châu.
Thanh Hương
17/04/2026
Mặc định
Lớn hơn
Khi xuất hiện các ổ mủ, vết thương nhiễm trùng hoặc viêm kéo dài không đáp ứng điều trị, nhiều người được chỉ định làm xét nghiệm cấy mủ. Vậy xét nghiệm cấy mủ là gì, có ý nghĩa ra sao và trong những trường hợp nào cần thực hiện?
Trong chẩn đoán và điều trị các bệnh nhiễm trùng, việc xác định chính xác tác nhân gây bệnh đóng vai trò then chốt. Xét nghiệm cấy mủ giúp bác sĩ xác định vi khuẩn, nấm hoặc các vi sinh vật gây nhiễm trùng, từ đó lựa chọn kháng sinh hoặc thuốc điều trị phù hợp.
Xét nghiệm cấy mủ là một kỹ thuật xét nghiệm vi sinh nhằm xác định loại vi khuẩn hoặc vi nấm gây nhiễm trùng trong các ổ mủ, dịch tiết từ vết thương, áp xe hoặc tổn thương viêm có mủ. Mẫu mủ sau khi được lấy đúng kỹ thuật sẽ được nuôi cấy trong môi trường thích hợp để vi sinh vật phát triển, từ đó giúp phòng xét nghiệm nhận diện chính xác tác nhân gây bệnh.
Không chỉ dừng lại ở việc xác định vi khuẩn, xét nghiệm cấy mủ còn thường được kết hợp với kháng sinh đồ nhằm đánh giá mức độ nhạy cảm hoặc đề kháng của vi khuẩn đối với từng loại kháng sinh. Nhờ vậy, bác sĩ có cơ sở lựa chọn phác đồ điều trị phù hợp, tránh dùng kháng sinh không hiệu quả hoặc gây kháng thuốc. Đây là xét nghiệm đặc biệt quan trọng trong các trường hợp nhiễm trùng nặng, nhiễm trùng tái phát hoặc không đáp ứng với điều trị ban đầu.
Xét nghiệm cấy mủ thường được chỉ định khi có ổ mủ, dịch tiết nghi ngờ nhiễm trùng, đặc biệt trong các trường hợp nhiễm trùng nặng, tái phát hoặc không đáp ứng với điều trị ban đầu. Cụ thể là:
Quy trình thực hiện xét nghiệm cấy mủ được tiến hành chuẩn từ khâu lấy mẫu, bảo quản đến nuôi cấy và phân tích, nhằm đảm bảo kết quả chính xác và có giá trị cho chẩn đoán, điều trị.
Bác sĩ hoặc nhân viên y tế sẽ tiến hành lấy mẫu mủ trực tiếp từ ổ nhiễm trùng bằng dụng cụ vô khuẩn. Cần lấy mẫu đúng vị trí, đủ lượng và hạn chế nhiễm bẩn để kết quả cấy mủ đảm bảo tính chính xác cao nhất.

Mẫu mủ được cho vào môi trường chuyên dụng và nhanh chóng chuyển đến phòng xét nghiệm. Việc bảo quản và vận chuyển đúng thời gian, đúng điều kiện giúp vi khuẩn còn sống, tránh sai lệch kết quả.
Tại phòng xét nghiệm, mẫu mủ được nuôi cấy trên các môi trường thích hợp. Sau một thời gian nuôi cấy, kỹ thuật viên sẽ quan sát sự phát triển của vi khuẩn để phân lập và định danh tác nhân gây nhiễm trùng.
Sau khi xác định vi khuẩn, xét nghiệm kháng sinh đồ được tiến hành nhằm đánh giá mức độ nhạy cảm hoặc kháng thuốc của vi khuẩn với từng loại kháng sinh, hỗ trợ lựa chọn thuốc điều trị phù hợp.
Kết quả cấy mủ và kháng sinh đồ được gửi cho bác sĩ điều trị. Dựa trên kết quả này, bác sĩ sẽ điều chỉnh phác đồ điều trị nhằm đạt hiệu quả cao và hạn chế nguy cơ kháng kháng sinh.
Xét nghiệm cấy mủ giúp xác định tác nhân gây nhiễm trùng trực tiếp tại ổ mủ, bao gồm:

Kết quả xét nghiệm cấy mủ có vai trò quan trọng trong việc xác định nguyên nhân gây nhiễm trùng và định hướng điều trị hiệu quả. Khi mẫu mủ cho kết quả dương tính, bác sĩ có thể xác định chính xác loại vi sinh vật gây bệnh (vi khuẩn, nấm, vi khuẩn kỵ khí…), từ đó lựa chọn kháng sinh hoặc thuốc kháng nấm phù hợp, tránh điều trị theo kinh nghiệm thiếu chính xác.
Bên cạnh việc phát hiện tác nhân, xét nghiệm cấy mủ thường được thực hiện kèm kháng sinh đồ, giúp đánh giá mức độ nhạy cảm hoặc đề kháng của vi khuẩn với từng loại kháng sinh. Điều này đặc biệt quan trọng trong bối cảnh vi khuẩn kháng thuốc ngày càng gia tăng, giúp giảm nguy cơ điều trị thất bại, kéo dài bệnh hoặc biến chứng nặng.
Trong trường hợp kết quả âm tính, bác sĩ sẽ xem xét các khả năng như nhiễm trùng do vi khuẩn khó nuôi cấy, đã dùng kháng sinh trước đó hoặc nguyên nhân không do vi sinh vật. Khi đó, hướng chẩn đoán và điều trị sẽ được điều chỉnh phù hợp hơn.
Thời gian trả kết quả xét nghiệm cấy mủ thường từ 2 - 5 ngày, tuy nhiên có thể ngắn hơn hoặc kéo dài hơn tùy loại vi sinh vật, đặc biệt với vi khuẩn kỵ khí hoặc nấm.
Trong nhiều trường hợp, kết quả sơ bộ có thể được trả sau 24 - 48 giờ, cho biết có hay không sự phát triển của vi khuẩn. Tuy nhiên, để có kết quả chính xác và đầy đủ, đặc biệt là phần kháng sinh đồ, thời gian thường kéo dài thêm 1 - 2 ngày. Với các vi khuẩn phát triển chậm hoặc vi khuẩn kỵ khí, thời gian chờ có thể lâu hơn.
Việc dùng kháng sinh trước khi lấy mẫu có thể làm kéo dài thời gian nuôi cấy hoặc khiến kết quả âm tính giả, ảnh hưởng đến hướng điều trị.

Chi phí xét nghiệm cấy mủ không cố định và phụ thuộc vào cơ sở y tế, loại vi sinh vật cần nuôi cấy (vi khuẩn hiếu khí, kỵ khí, nấm), việc thực hiện kháng sinh đồ cũng như quy định viện phí hiện hành. Người bệnh nên tham khảo bảng giá niêm yết chính thức tại cơ sở y tế công lập hoặc theo danh mục bảo hiểm y tế để biết chi phí cụ thể.
Theo thực tế triển khai tại các cơ sở y tế công lập, chi phí xét nghiệm cấy mủ thường dao động trong khoảng 150.000 – 500.000 VNĐ, tùy loại vi sinh vật nuôi cấy (vi khuẩn hiếu khí, kỵ khí, nấm), có hay không kháng sinh đồ và quy định viện phí của từng cơ sở.
Tại các bệnh viện công, trung tâm xét nghiệm lớn, chi phí thường được niêm yết theo bảng giá chung của đơn vị và có thể thấp hơn so với các phòng khám tư nhân. Nếu khám tại bệnh viện có bảo hiểm y tế, một phần chi phí xét nghiệm cũng có thể được bảo hiểm chi trả theo quy định hiện hành.
Để kết quả xét nghiệm cấy mủ phản ánh đúng tác nhân gây bệnh, người bệnh cần tuân thủ một số lưu ý quan trọng sau:
Tìm hiểu những câu hỏi thường gặp về xét nghiệm cấy mủ giúp người bệnh yên tâm hơn khi thực hiện.
Xét nghiệm cấy mủ không yêu cầu nhịn ăn, vì đây là xét nghiệm vi sinh dựa trên mẫu mủ tại vị trí nhiễm trùng, không liên quan đến chuyển hóa thức ăn trong cơ thể. Người bệnh có thể ăn uống và sinh hoạt bình thường trước khi lấy mẫu, trừ khi được chỉ định thực hiện đồng thời các xét nghiệm cần nhịn ăn khác.
Xét nghiệm cấy mủ nhìn chung an toàn và ít xâm lấn khi được thực hiện đúng kỹ thuật vô khuẩn bởi nhân viên y tế có chuyên môn. Quá trình lấy mẫu thường chỉ gây cảm giác khó chịu nhẹ hoặc đau thoáng qua tại vị trí tổn thương. Khi được thực hiện đúng kỹ thuật vô khuẩn bởi nhân viên y tế, nguy cơ nhiễm trùng hay ảnh hưởng đến sức khỏe gần như không đáng kể.
Mẫu mủ được lấy trực tiếp từ ổ mủ hoặc vùng tổn thương nghi ngờ nhiễm trùng, như áp xe da, vết thương nhiễm khuẩn, vết mổ có mủ hoặc ổ viêm sâu. Việc lấy mẫu đúng vị trí giúp phản ánh chính xác tác nhân gây bệnh, từ đó hỗ trợ bác sĩ lựa chọn phương pháp điều trị phù hợp và hiệu quả hơn.
Xét nghiệm cấy mủ là công cụ chẩn đoán quan trọng giúp xác định chính xác vi khuẩn gây nhiễm trùng và định hướng điều trị hiệu quả, đặc biệt trong các trường hợp nhiễm trùng nặng hoặc tái phát. Thực hiện xét nghiệm đúng thời điểm sẽ giúp hạn chế lạm dụng kháng sinh và giảm nguy cơ biến chứng cho người bệnh.
Dược sĩ Đại họcNguyễn Vũ Kiều Ngân
Tốt nghiệp Đại học Y Dược TP. Hồ Chí Minh. Có nhiều năm trong lĩnh vực dược phẩm. Hiện đang là giảng viên cho Dược sĩ tại Nhà thuốc Long Châu.